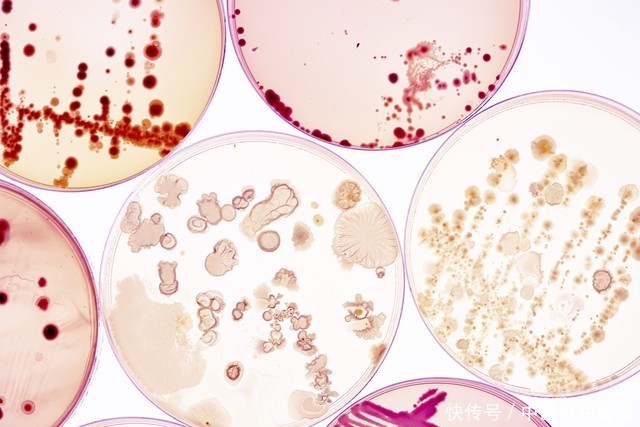

连年来,对于“坏”胆固醇(低密度脂卵白胆固醇,LDL-C)与健康的联系,科学界有了新的领会。传统不雅点以为,LDL-C水平越低越故意于心血管健康,但多项商议揭示,LDL-C并非越低越好,其水平与脑出血风险之间存在复杂关联。 低密度脂卵白胆固醇的“双刃剑”效应 低密度脂卵白胆固醇精采将胆固醇运载到全身细胞,是保管生理功能的迫切物资。关联词,当其水平过高时,阔气的胆固醇会在血管壁千里积,造成动脉粥样硬化斑块,增多心脑血管疾病风险。因此,LDL-C被称为“坏”胆固醇,责备其水平一直是心血管疾病防控的

连年来,对于“坏”胆固醇(低密度脂卵白胆固醇,LDL-C)与健康的联系,科学界有了新的领会。传统不雅点以为,LDL-C水平越低越故意于心血管健康,但多项商议揭示,LDL-C并非越低越好,其水平与脑出血风险之间存在复杂关联。
低密度脂卵白胆固醇的“双刃剑”效应低密度脂卵白胆固醇精采将胆固醇运载到全身细胞,是保管生理功能的迫切物资。关联词,当其水平过高时,阔气的胆固醇会在血管壁千里积,造成动脉粥样硬化斑块,增多心脑血管疾病风险。因此,LDL-C被称为“坏”胆固醇,责备其水平一直是心血管疾病防控的中枢战略。
但连年来商议发现,LDL-C水平过低可能带来新的健康隐患。国内一项掩盖15家病院、纳入6387例75岁以上动脉粥样硬化性心血管病患者的商议浮现,当LDL-C水平低于1.04mmol/L时,脑出血风险会权贵增多。另一项基于英国生物样本库的大范围队伍商议也发现,LDL-C水平与脑出血风险呈负关联,即LDL-C越低,脑出血风险越高。
机制理会:为何低LDL-C会增多脑出血风险?血管壁的完好意思性依赖于多种脂卵白的均衡。LDL-C过低时,血管壁的设立智商可能消弱,同期,低LDL-C现象可能影响血小板功能和凝血机制,增多血管离散的风险。此外,他汀类药物当作常用的降脂药物,天然能有用责备LDL-C水平,但部分商议指示其可能通过责备LDL-C曲折增多脑出血风险,不外这种风险完全值较低,且降脂的获益仍雄伟于潜在风险。
血脂限度的安全范围在那边?阐述《中国血脂科罚指南(2023年)》,不同东说念主群的LDL-C限度主义不同:
平时健康东说念主群:LDL-C应低于3.4mmol/L;高危东说念主群(如糖尿病患者、高血压患者):LDL-C需限度在2.6mmol/L以下;极高危东说念主群(如已确诊冠心病、脑梗死患者):LDL-C应低于1.8mmol/L,且降幅需普及基线水平的50%;超高危东说念主群(如屡次发生心脑血作事件的患者):限度更为严格,需在大夫开采下设定个体化主义。对于老年东说念主群,尤其是75岁以上的乐龄患者,商议薄情LDL-C水平不宜过低。若LDL-C低于1.4mmol/L,需密切监测脑出血风险,必要时调治调治决策。
均衡风险与获益的科学战略责备LDL-C已经心血管疾病防控的枢纽,但需幸免“一刀切”的过度责备。以下治安有助于均衡风险与获益:
个体化调治:阐述年事、基础疾病、眷属史等身分,在大夫开采下设定合理的LDL-C主义值。概述科罚:除限度LDL-C外,还需热心血压、血糖、同型半胱氨酸等其他心脑血管疾病危境身分。活命花样干与:通过合理饮食(减少饱和脂肪摄入,增多膳食纤维)、规定通顺(每玉成少150分钟中等强度有氧通顺)、戒烟限酒等花样,缓助责备LDL-C水平。依期监测:40岁以上东说念主群应每年检测血脂,高危东说念主群需镌汰检测断绝,以便实时调治调治决策。
低密度脂卵白胆固醇与健康的联系并非浅近的“越低越好”,而是需要找到一个均衡点。通过科学的科罚战略,咱们既能责备心血管疾病风险,又能幸免因LDL-C过低带来的潜在危害。